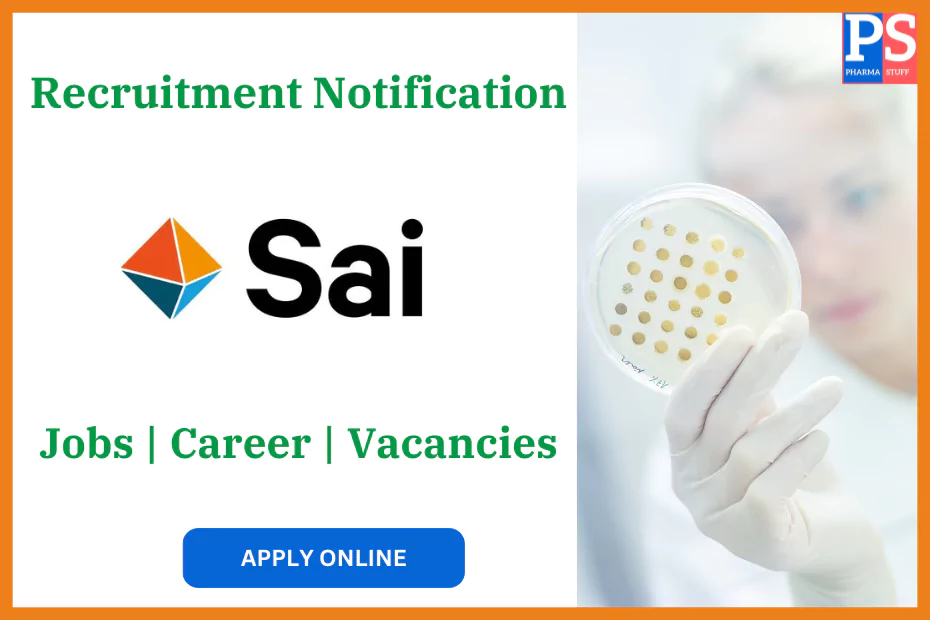
sai life sciences career reequipment job vacancies

Sai Life Sciences Walk-In Drive for Process R&D Roles
- Walk-In Drive Details for Process R&D Roles at Sai Life Sciences
- Open Positions for Process R&D in Hyderabad
- Event and Application Instructions
Sai Life Sciences, a Contract Development and Manufacturing Organization (CDMO) sector, is conducting a walk-in drive for Process R&D roles. This event is ideal for MSc and Ph.D. holders in Organic Chemistry, offering an opportunity to work in Shamirpet, Hyderabad.
Walk-In Drive Details for Process R&D Roles at Sai Life Sciences
Sai Life Sciences invites candidates with expertise in Process R&D to participate in its walk-in drive. Qualified professionals will have the opportunity to meet with hiring managers and learn more about the company’s vision and projects.
- Date: Sunday, November 10, 2024
- Time: 9:00 AM to 2:00 PM
- Location: Sai Life Sciences Ltd., SLN Terminus, 4th Floor, Gachibowli Miyapur Road, Hyderabad
Candidates are encouraged to scan the QR code on the official event page to submit their CVs in advance.
Open Positions for Process R&D in Hyderabad
Qualifications and Experience Requirements:
- MSc in Organic Chemistry: 2-8 years of experience in a similar role.
- Ph.D. or Post-Doc in Organic Chemistry: 0-3 years of experience in process research and development.
Key Responsibilities:
Candidates selected for Process R&D roles at Sai Life Sciences will work on various tasks in synthetic organic chemistry and process optimization, including:
- API and Intermediate Synthesis: Apply hands-on expertise in the synthesis of active pharmaceutical ingredients (APIs) and advanced intermediates.
- Route Design & Process Development: Design and scout new chemical routes for the scale-up of raw materials, intermediates, and APIs.
- Laboratory Safety and Protocols: Adhere to stringent safety guidelines to ensure safe laboratory operations.
- Team Collaboration: Work collaboratively with cross-functional teams and communicate effectively across departments.
Event and Application Instructions
To participate in the walk-in drive:
- Bring an updated resume, academic certificates, and any relevant project documentation.
- Submit your CV ahead of time by scanning the QR code provided by Sai Life Sciences (available on the event page).


